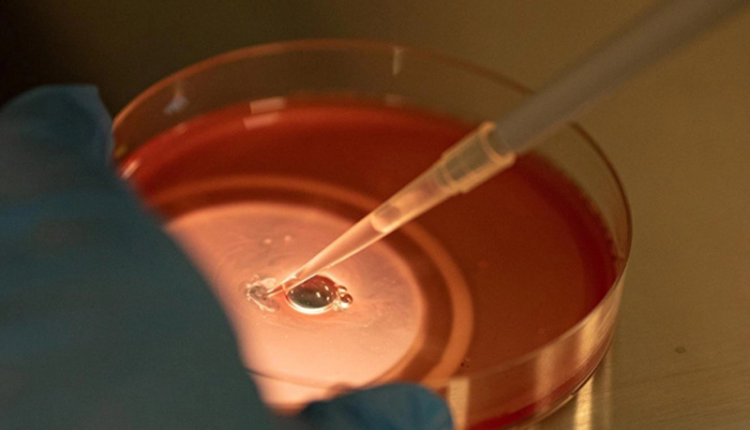

“Vét” tinh trùng cho người đàn ông đột biến gene AZF
Anh Minh, 36 tuổi, tinh trùng cực kỳ hiếm hoi do đột biến gene AZF, bác sĩ “vét” được 9 tinh binh để thụ tinh trong ống nghiệm giúp anh có con.
Anh Minh (ngụ Long An) kết hôn năm 2015. Sau hai năm chưa có con, vợ chồng anh đi khám, phát hiện không có tinh trùng. Bác sĩ chỉ định phẫu thuật TESE trích tinh trùng từ tinh hoàn; nếu không tìm thấy tinh trùng phương án tiếp theo là xin tinh trùng để thực hiện thụ tinh ống nghiệm (IVF). Anh Minh trì hoãn.
Nhiều năm trời vẫn không có chuyển biến, tháng 4/2023 vợ chồng anh đến Trung tâm Hỗ trợ Sinh sản, BVĐK Tâm Anh TP HCM khám toàn diện về sức khỏe sinh sản.
Bác sĩ Ngô Đình Triệu Vỹ cho biết, kết quả tinh dịch đồ của anh Minh cho thấy số lượng tinh trùng cực kỳ hiếm hoi, độ di động kém. Trung bình mỗi lần xuất tinh của nam giới sản xuất ra 39 triệu tinh trùng thì ở anh Minh chỉ ghi nhận được 1-2 tinh trùng. Xét nghiệm AZF (xét nghiệm gene xác định yếu tố gây vô tinh ở nam giới) cho thấy anh Minh bị đột biến gene mất tiểu vùng AZFc.
AZF (Azoospermia factor) là vùng được mã hóa nằm trên nhánh dài của nhiễm sắc thể Y ở nam giới. AZF gồm các tiểu vùng AZFa, AZFb, AZFc, chứa các gene quyết định khả năng sản xuất tinh trùng. Mất AZFc dẫn đến giảm mạnh số lượng tinh trùng, gây vô sinh nam.
Theo bác sĩ Vỹ, đột biến AZF là thủ phạm gây 15-30% trường hợp vô sinh nam. Nguyên nhân đột biến có thể do di truyền, sự tái tổ hợp thay đổi cấu trúc nhiễm sắc thể.

Nhiều trường hợp người bệnh cần mổ trích tinh trùng từ tinh hoàn (Testicular Sperm Extraction – TESE) hoặc các phương pháp khác. Tuy nhiên, với anh Minh thì chưa cần áp dụng. Bác sĩ Vỹ chọn cách thu thập nhiều mẫu tinh dịch hơn thông thường và áp dụng phương pháp quay ly tâm, tức sử dụng hai lớp dung dịch để chọn lọc tinh trùng.
Với phương pháp này, các tế bào lạ, tinh trùng chết, dị tật được giữ lại ở lớp lọc. Những tinh binh khỏe mạnh, di động tốt sẽ vượt qua màng lọc, di chuyển xuống đáy ống ly tâm. Kỹ thuật viên phôi học dựa vào hình dạng để đánh giá và “vét” được 9 tinh trùng để trữ đông.
Chị Ánh, vợ anh Minh, bị buồng trứng đa nang. Bác sĩ Vỹ chọc hút được 15 noãn, tạo được 5 phôi. Cuối tháng 6, chị được chuyển một phôi vào tử cung và đậu thai ngay lần đầu. Thai nhi hiện 10 tuần, phát triển khỏe mạnh. Các phôi còn lại được trữ đông giúp họ có cơ hội sinh thêm con.
“Trước đó tôi đã chuẩn bị tâm lý và kinh tế sẵn sàng cho cuộc mổ nhưng may mắn là các bác sĩ tìm được căn nguyên, giúp tôi không phải mổ mà vẫn có con của chính mình”, anh Minh nói.
Theo bác sĩ Vỹ, nam giới đột biến AZF nếu sinh con trai nên xét nghiệm tinh trùng cho trẻ ngay khi dậy thì bởi có khả năng di truyền. Tùy tình trạng, người bệnh vẫn có khả năng tìm thấy tinh trùng, bảo tồn kịp thời, có con bằng thụ tinh ống nghiệm.
Vợ chồng kết hôn sau một năm, quan hệ tình dục đều đặn và không tránh thai mà chưa có con nên khám toàn diện sức khỏe sinh sản của cả hai. Trường hợp mật độ tinh trùng dưới 5 triệu/ml, vô tinh không do tắc nghẽn, tiền căn sinh con dị tật… bệnh nhân được xét nghiệm AZF nhằm xác định căn nguyên gây vô sinh.
Hiện nay có nhiều phương pháp hỗ trợ sinh sản cho người bệnh, như kỹ thuật trích tinh trùng từ tinh hoàn và mào tinh (PESA, PESE, micro-TESE) hoặc tìm tinh trùng trong cặn lắng ly tâm, sau đó tiêm vào bào tương trứng. Tùy tình trạng, bác sĩ đưa ra phương pháp điều trị phù hợp, tăng khả năng có con, tiết kiệm chi phí, giảm biến chứng do các cuộc mổ chưa cần thiết.
Ngoài ra, Quý khách hàng có thể tham khảo thêm sản phẩm Menpro chính hãng có bán tại Hệ Thống Nhà Thuốc Gia Hân Pharmacy & giao hàng trên toàn quốc.
Hệ Thống Nhà Thuốc Gia Hân Pharmacy là nơi Quý khách hàng yên tâm gửi trọn niềm tin để chăm sóc sức khoẻ cho cả gia đình mình.
Đến với chúng tôi, Quý khách hàng thoải mái trải nghiệm cảm giác mua sắm hàng chính hãng với giá tốt nhất đầy đủ các sản phẩm thuốc tây, thực phẩm bảo vệ sức khoẻ, mỹ phẩm, thiết bị y tế…

Comments are closed.